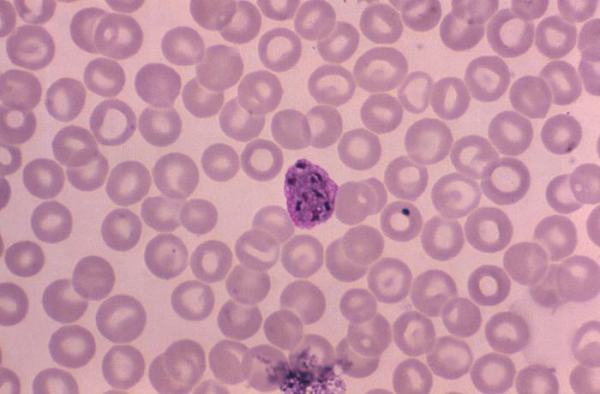

New WWARN literature review explores the global extent of resistance in P. vivax
29 Jan 2015
WWARN Published Date
Our understanding of the extent and nature of resistance in P. vivax parasites is largely unknown. WWARN’s new literature review summarises the global extent of reduced P. vivax susceptibility to the frontline antimalarial chloroquine. You can also download our new generic P. vivax protocol - we welcome your feedback.
Read a full summary of the literature review.